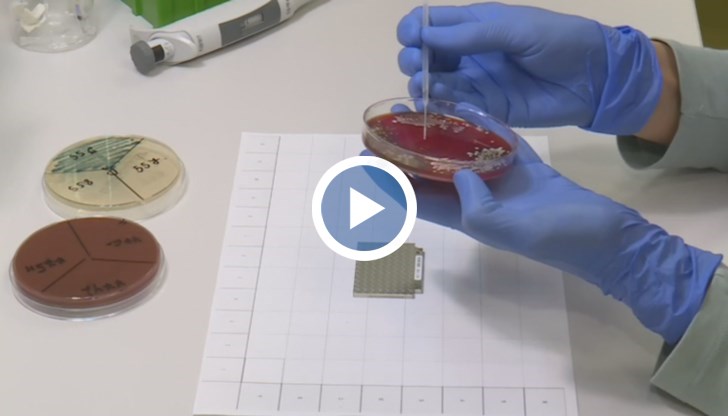

Русенска лаборатория прави безплатни изследвания на бежанци от Украйна
- Редактор: Петър Симеонов
- Коментари: 4
0
Лабораторията има готовност да бъдат назначени на работа украински специалисти
Лабораторията има готовност да бъдат назначени на работа украински специалисти
Русенска медицинска лаборатория предлага безплатни изследвания за бежанци от Украйна. Тя има готовност да бъдат назначени на работа украински специалисти, предаде БНТ.
Лабораторията разполага и с един от двата най-модерни за страната апарати за микробиологични анализи, който прави прецизни изследвания за броени минути.
Изпращайте снимки и информация на news@dunavmost.com по всяко време на денонощието!




















